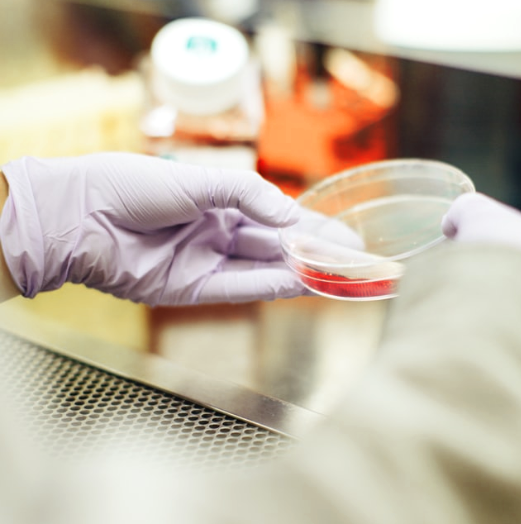
Product Safety and Consistency Saves Lives

Blog
Are You Prepared for a Break In?
We tend to think of our homes as bastions of privacy and safety, but the FBI reported 41 percent of...
Parking Garage Safety
We’ve all seen the stories of people being attacked in parking garages. So what’s the best way to stay safe...
The Necessity of Self Defense
The ultimate line of defense in any situation is you. We’re all guilty of thinking “it will never happen to...
Every Day Self Defense Techniques
Carrying a less lethal device is a great way to protect yourself, gain confidence, and take control of your personal...
Safe Travels with HERO®
There’s a whole wide world of amazing places waiting to be discovered. And while each destination offers its own unique...
Welcome to HERO Defense Systems
We all want to keep our loved ones safe. At home, at school, at the store, and everywhere in between....
Product Safety and Consistency Saves Lives
When it comes to self defense products, we understand the importance of quality and consistency. Defects in products like pepper...
The Growing Need for Less Lethal Protection Devices
Unfortunately we live in a world where news of people being attacked is a regular occurrence. In fact, 58% of...
Less Lethal Innovation at the 2020 Shot Show
Join us in Las Vegas on January 21st - 24th to see the new HERO® 2020! Our founders were inspired...